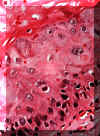

| |
|
Salud
Dental
 Para Todos
Para Todos |
| |
|
Microscopía de la displasia mucosa |
|
Escuela Dental de la Universidad del Sur de
California. U.S.A.
|
|
|
| Opuesta a la queratosis benigna, la displasia de la
mucosa ofrece anormalidades celulares significantes en el epitelio.
Esta microfotografía del epitelio escamoso normal,
que esencialmente es uniforme en un lado con una línea afilada de
demarcación entre este y el epitelio anormal en el otro. Incluso a
estos aumentos (resolución baja) uno puede descubrir la variación en
el tamaño, forma y pigmentación de las células. No hay ninguna invasión
del epitelio hacia el tejido conjuntivo. Esta es la característica que
distingue a la displasia de la mucosa del carcinoma espinocelular. |
 |
|
Con más aumento,
la displasia muestra queratina en la superficie, agrandamiento de los núcleos,
variación en la cantidad del citoplasma, variación en la morfología y
tamaño nuclear, desorientación en la capa celular basal y
queratinización prematura y degeneración celular. |
 |
|
Esto es un grado de displasia severa
que muestra sólo
paraqueratina atípica en la superficie y pobre maduración
de la capa celular basal. |
 |
| Aunque alguna queratina cubre la superficie, debe
considerarse que esta es un displasia severa.
Las células son inmaduras e hipercromáticas y hay
marcado aumento en la relación núcleo-citoplasma. |
 |
|
Para repasar la diferencia entre el
epitelio normal y epitelio displásico usted debe comparar esta imagen
que es normal con la imagen anterior. |
 |
|